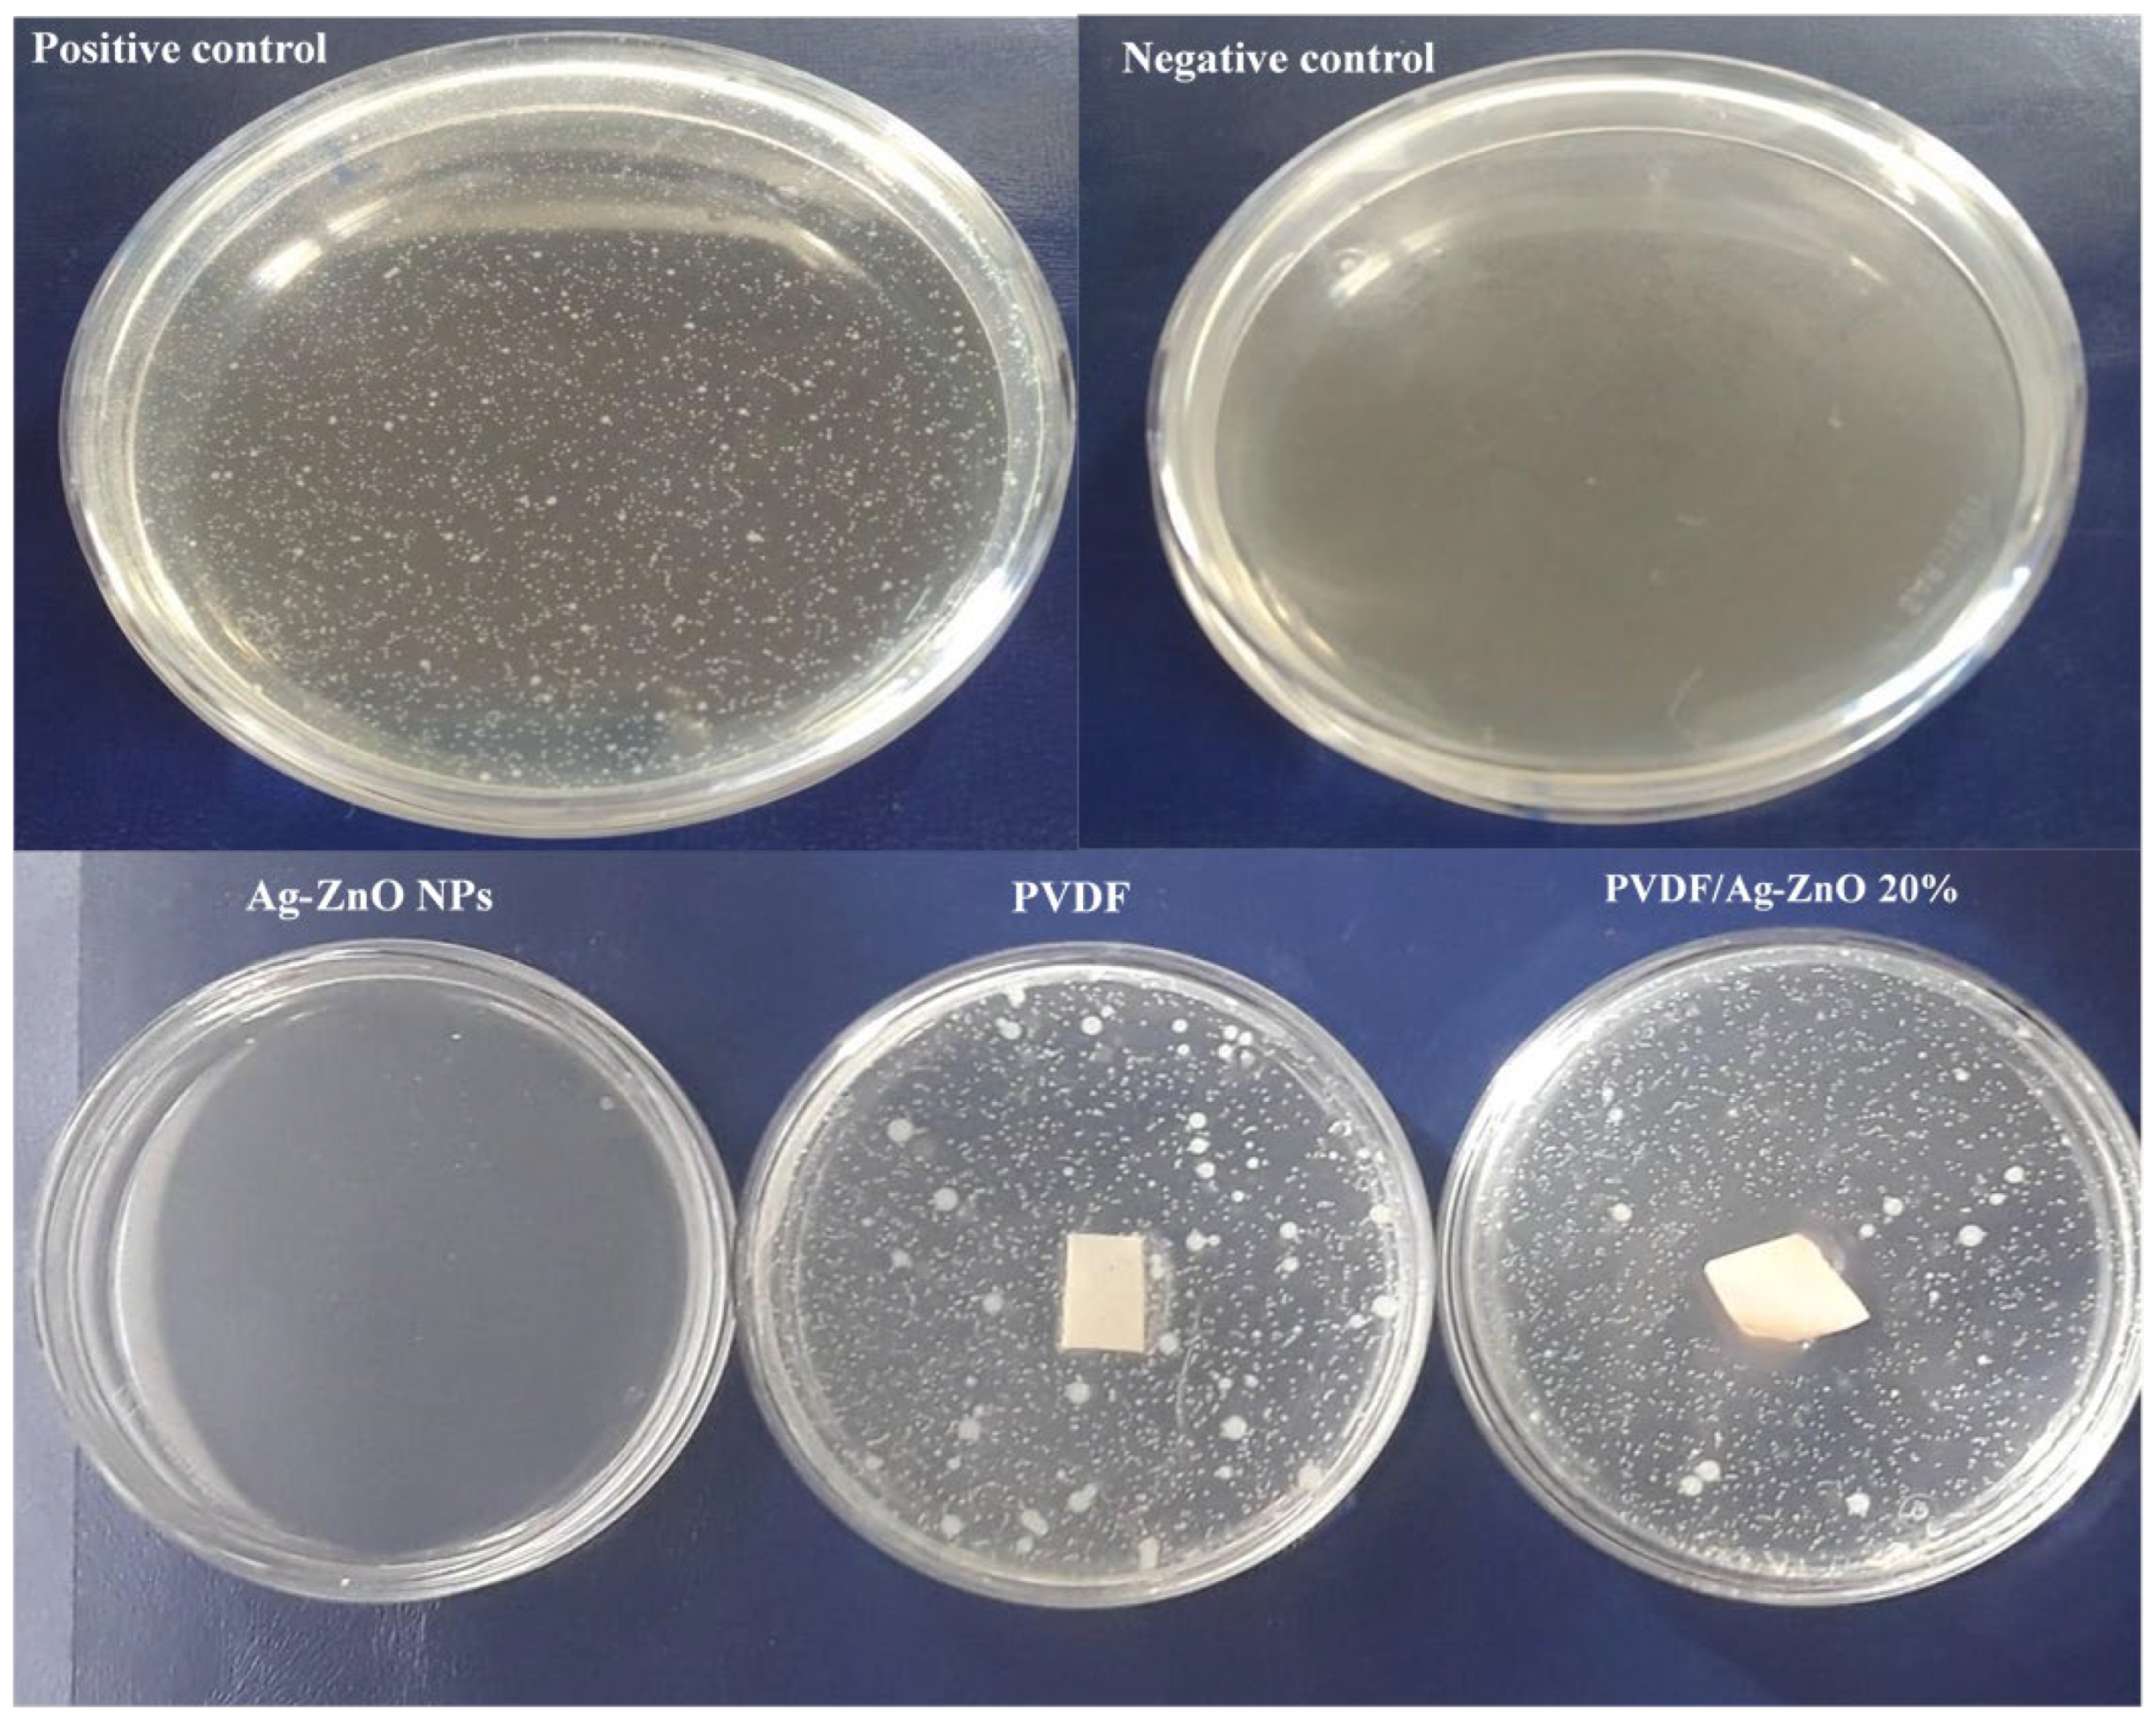
Polymers 17 01269 g007

Incorporation of Ag-ZnO Nanoparticles into PVDF Membrane Formulation to Enhance Dye Retention, Permeability, and Antibacterial Properties
Abstract
1. Introduction
2. Materials and Methods
2.1. Chemicals Reagents
2.2. Ag-ZnO Nanoparticles Preparation
2.3. Membrane Synthesis by Non-Solvent-Induced Phase Separation Technique (NIPS)
2.4. Membrane Characterization
2.5. Membranes Performance
3. Results
3.1. PVDF and PVDF/Ag-ZnO Composite Membranes Composition
3.2. PVDF and PVDF/Ag-ZnO Composite Membrane Characterization
3.3. Membranes Permeability
3.4. Adsorption Study of RB5 on Composite Membranes in Static Mode
3.5. Antibacterial Test
4. Conclusions
Author Contributions
Funding
Institutional Review Board Statement
Data Availability Statement
Conflicts of Interest
References
- Shi, J.; Wang, Y.; Lu, S.; Wang, J.; Liu, J. Pilot study on ceramic flat membrane bioreactor in treatment of coal chemical wastewater. Chemosphere 2024, 347, 140701. [Google Scholar] [CrossRef]
- Chamam, B.; Heran, M.; Amar, R.B.; Grasmick, A. Comparison of textile dye treatment by biosorption and membrane bioreactor. Environ. Technol. 2007, 28, 1325–1331. [Google Scholar] [CrossRef] [PubMed]
- Kammakakam, I.; Lai, Z. Next-generation ultrafiltration membranes: A review of material design, properties, recent progress, and challenges. Chemosphere 2023, 316, 137669. [Google Scholar] [CrossRef] [PubMed]
- Siagian, U.W.R.; Khoiruddin, K.; Wardani, A.K.; Aryanti, P.T.P.; Widiasa, I.N.; Qiu, G.; Ting, Y.P.; Wenten, I.G. High-performance ultrafiltration membrane: Recent progress and its application for wastewater treatment. Curr. Pollut. Rep. 2021, 7, 448–462. [Google Scholar] [CrossRef]
- Khan, S.; Mansoor, S.; Rafi, Z.; Kumari, B.; Shoaib, A.; Saeed, M.; Alshehri, S.; Ghoneim, M.M.; Rahamathulla, M.; Hani, U.; et al. A review on nanotechnology: Properties, applications, and mechanistic insights of cellular uptake mechanisms. J. Mol. Liq. 2022, 348, 118008. [Google Scholar] [CrossRef]
- Keller, A.A.; Ehrens, A.; Zheng, Y.; Nowack, B. Developing trends in nanomaterials and their environmental implications. Nat. Nanotechnol. 2023, 18, 834–837. [Google Scholar] [CrossRef] [PubMed]
- Ben Dassi, R.; Chamam, B.; Méricq, J.P.; Heran, M.; Faur, C.; El Mir, L.; Tizaoui, C.; Trabelsi, I. Pb doped ZnO nanoparticles for the sorption of Reactive Black 5 textile azo dye. Water Sci. Technol. A J. Int. Assoc. Water Pollut. Res. 2020, 82, 2576–2591. [Google Scholar] [CrossRef]
- Selmani, A.; Kovačević, D.; Bohinc, K. Nanoparticles: From synthesis to applications and beyond. Adv. Colloid Interface Sci. 2022, 303, 102640. [Google Scholar] [CrossRef]
- Ajith, M.P.; Aswathi, M.; Priyadarshini, E.; Rajamani, P. Recent innovations of nanotechnology in water treatment: A comprehensive review. Bioresour. Technol. 2021, 342, 126000. [Google Scholar] [CrossRef]
- Thamarai, P.; Kamalesh, R.; Saravanan, A.; Swaminaathan, P.; Deivayanai, V.C. Emerging trends and promising prospects in nanotechnology for improved remediation of wastewater contaminants: Present and future outlooks. Environ. Nanotechnol. Monit. Manag. 2024, 10, 100913. [Google Scholar] [CrossRef]
- García-Ivars, J.; Corbatón-Báguena, M.J.; Iborra-Clar, M.I. Development of Mixed Matrix Membranes: Incorporation of Metal Nanoparticles in Polymeric Membranes. In Nanoscale Materials in Water Purification; Elsevier: Amsterdam, The Netherlands, 2019; pp. 153–178. [Google Scholar]
- Song, Z.; Fathizadeh, M.; Huang, Y.; Chu, K.H.; Yoon, Y.; Wang, L.; Xu, W.L.; Yu, M. TiO2 nanofiltration membranes prepared by molecular layer deposition for water purification. J. Membr. Sci. 2016, 510, 72–78. [Google Scholar] [CrossRef]
- El Mir, L.; Omri, K.; El Ghoul, J.; Al-Hobaib, A.S.; Dahman, H.; Barthou, C. Yellow emission of SiO2/Zn2SiO4:Mn nanocomposite synthesized by sol–gel method. Superlattices Microstruct. 2014, 65, 248–255. [Google Scholar] [CrossRef]
- Ben Dassi, R.; Chamam, B.; Méricq, J.P.; Faur, C.; El Mir, L.; Trabelsi, I.; Heran, M. Novel polyvinylidene fluoride/lead-doped zinc oxide adsorptive membranes for enhancement of the removal of reactive textile dye. Int. J. Environ. Sci. Technol. 2020, 18, 2793–2804. [Google Scholar] [CrossRef]
- Elessawy, N.A.; Gouda, M.H.; Elnouby, M.; Ali, S.M.; Salerno, M.; Youssef, M.E. Sustainable Microbial and Heavy Metal Reduction in Water Purification Systems Based on PVA/IC Nanofiber Membrane Doped with PANI/GO. Polymers 2022, 14, 1558. [Google Scholar] [CrossRef]
- Yan, H.F.; Luo, L.H.; Xu, Z.L.; Fang, Y.X.; Pandaya, D.; Dai, J.Y.; Liang, J.; Xu, S.J. Incorporating etched ZnO nanoparticles to fabricate positively charged composite membrane for heavy metal removal. Desalination 2024, 574, 117275. [Google Scholar] [CrossRef]
- Sonawane, S.; Thakur, P.; Sonawane, S.H.; Bhanvase, B.A. Nanomaterials for Membrane Synthesis: Introduction, Mechanism, and Challenges for Wastewater Treatment. In Handbook of Nanomaterials for Wastewater Treatment; Elsevier: Amsterdam, The Netherlands, 2021; pp. 537–553. [Google Scholar] [CrossRef]
- Sanoja-López, K.A.; Quiroz-Suárez, K.A.; Dueñas-Rivadeneira, A.A.; Maddela, N.R.; Montenegro, M.C.; Luque, R.; Rodríguez-Díaz, J.M. Polymeric membranes functionalized with nanomaterials (MP@ NMs): A review of advances in pesticide removal. Environ. Res. 2023, 217, 114776. [Google Scholar] [CrossRef]
- Khdary, N.H.; Almuarqab, B.T.; El Enany, G. Nanoparticle-embedded polymers and their applications: A review. Membranes 2023, 13, 537. [Google Scholar] [CrossRef] [PubMed]
- Chamam, B.; Dassi, R.B.; Jraba, A.; Mokni, S.; Trabelsi, I.; Heran, M.; El Mir, L. One-step Ag-doped ZnO nanoparticle synthesis for textile azo dye sorption and antibacterial activity. Euro-Mediterr. J. Environ. Integr. 2025, 10, 101–117. [Google Scholar] [CrossRef]
- Wu, H.; Mansouri, J.; Chen, V. Silica nanoparticles as carriers of antifouling ligands for PVDF ultrafiltration membranes. J. Membr. Sci. 2013, 433, 135–151. [Google Scholar] [CrossRef]
- Tan, X.; Rodrigue, D. A review on porous polymeric membrane preparation. Part I: Production techniques with polysulfone and poly (vinylidene fluoride). Polymers 2019, 11, 1160. [Google Scholar] [CrossRef]
- Yan, L.; Hong, S.; Li, M.L.; Li, Y.S. Application of the Al2O3–PVDF nanocomposite tubular ultrafiltration (UF) membrane for oily wastewater treatment and its antifouling research. Sep. Purif. Technol. 2009, 66, 347–352. [Google Scholar] [CrossRef]
- Valamohammadi, E.; Behdarvand, F.; Tofighy, M.A.; Mohammadi, T. Preparation of positively charged thin-film nanocomposite membranes based on the reaction between hydrolyzed polyacrylonitrile containing carbon nanomaterials and HPEI for water treatment application. Sep. Purif. Technol. 2020, 242, 116826. [Google Scholar] [CrossRef]
- Ma, C.; Hu, J.; Sun, W.; Ma, Z.; Yang, W.; Wang, L.; Ran, Z.; Zhao, B.; Zhang, Z.; Zhang, H. Graphene oxide-polyethylene glycol incorporated PVDF nanocomposite ultrafiltration membrane with enhanced hydrophilicity, permeability, and antifouling performance. Chemosphere 2020, 253, 126649. [Google Scholar] [CrossRef]
- Bubela, H.; Konovalova, V.; Kujawa, J.; Kolesnyk, I.; Burban, A.; Kujawski, W. Enhancing of transport parameters and antifouling properties of PVDF membranes modified with Fe3O4 nanoparticles in the process of proteins fractionation. Sep. Purif. Technol. 2023, 325, 124573. [Google Scholar] [CrossRef]
- Bagha, G.; Samavati, K.; Naffakh-Moosavy, H.; Matin, L.F. Controlling surface morphology of Ag-doped ZnO as a buffer layer by dispersion engineering in planar perovskite solar cells. Sci. Rep. 2024, 14, 4617. [Google Scholar] [CrossRef]
- Kandulna, R.; Choudhary, R.B.; Maji, P. Ag-doped ZnO reinforced polymeric Ag: ZnO/PMMA nanocomposites as electron transporting layer for OLED application. J. Inorg. Organomet. Polym. Mater. 2017, 27, 1760–1769. [Google Scholar] [CrossRef]
- El-Nahhal, I.M.; Salem, J.; Anbar, R.; Kodeh, F.S.; Elmanama, A. Preparation and antimicrobial activity of ZnO-NPs coated cotton/starch and their functionalized Ag-ZnO/cotton and Zn (II) curcumin/cotton materials. Sci. Rep. 2020, 10, 5410. [Google Scholar]
- Naseem, T.; Durrani, T. The role of some important metal oxide nanoparticles for wastewater and antibacterial applications: A review. Environ. Chem. Ecotoxicol. 2021, 3, 59–75. [Google Scholar] [CrossRef]
- Asiri, A.M.; Pugliese, V.; Coppola, G.; Khan, S.B.; Alamry, K.A.; Alfifi, S.Y.; Chakraborty, S. Zinc oxide nanoparticles immobilized on polymeric porous matrix for water remediation. Emergent Mater. 2024, 7, 1531–1544. [Google Scholar] [CrossRef]
- Bai, H.; Wang, X.; Zhou, Y.; Zhang, L. Preparation and characterization of poly (vinylidene fluoride) composite membranes blended with nanocrystalline cellulose. Prog. Nat. Sci. Mater. Int. 2012, 22, 250–257. [Google Scholar] [CrossRef]
- Arsyad, A.; Saaid, F.I.; Najihah, M.Z.; Tan, W. FTIR studies on interactions among components in PVdF-HFP:PC:MPII electrolytes. IOP Conf. Ser. Earth Environ. Sci. 2023, 1151, 012060. [Google Scholar] [CrossRef]
- Zamiri, R.; Rebelo, A.; Zamiri, G.; Adnani, A.; Kuashal, A.; Belsley, M.S.; Ferreira, J.M. Far-infrared optical constants of ZnO and ZnO/Ag nanostructures. RSC Adv. 2014, 4, 20902–20908. [Google Scholar] [CrossRef]
- Santos, B.P.S.; Arias, J.J.R.; Jorge, F.E.; de Deus Santos, R.É.P.; da Silva Fernandes, B.; da Silva Candido, L.; Peres, A.C.d.C.; Chaves, E.G.; Marques, M.d.F.V. Preparation, characterization and permeability evaluation of poly (vinylidene fluoride) composites with ZnO particles for flexible pipelines. Polym. Test. 2021, 94, 107064. [Google Scholar] [CrossRef]
- Chen, F.; Jing, M.X.; Yang, H.; Yuan, W.Y.; Liu, M.Q.; Ji, Y.S.; Hussain, S.; Shen, X.Q. Improved ionic conductivity and Li dendrite suppression of PVDF-based solid electrolyte membrane by LLZO incorporation and mechanical reinforcement. Ionics 2021, 27, 1101–1111. [Google Scholar] [CrossRef]
- Sharma, M.; Madras, G.; Bose, S. PVDF membranes containing hybrid nanoparticles for adsorbing cationic dyes: Physical insights and mechanism. Mater. Res. Express 2016, 3, 075303. [Google Scholar] [CrossRef]
- Lin, H.; Ding, Y. Polymeric membranes: Chemistry, physics, and applications. J. Polym. Sci. 2020, 58, 2433–2434. [Google Scholar] [CrossRef]
- Mpala, T.J.; Richards, H.; Etale, A.; Mahlangu, O.T.; Nthunya, L.N. Carbon nanotubes and silver nanoparticles modification of PVDF membranes for improved seawater desalination in direct contact membrane distillation. Front. Membr. Sci. Technol. 2023, 2, 1165678. [Google Scholar] [CrossRef]

| Membranes | PVDF | PVDF/Ag-ZnO-5% | PVDF/Ag-ZnO-10% | PVDF/Ag-ZnO-20% | ||||
|---|---|---|---|---|---|---|---|---|
| %Mass | %Atomic | %Mass | %Atomic | %Mass | %Atomic | %Mass | %Atomic | |
| F | 57.99 | 46.71 | 56.15 | 46.06 | 49.63 | 41.19 | 40.90 | 35.86 |
| Zn | 0.00 | 0.00 | 2.52 | 0.60 | 6.35 | 1.53 | 14.43 | 3.68 |
| Ag | 0.00 | 0.00 | ND * | ND * | ND * | ND * | 0.29 | 0.05 |
| PVDF | PVDF/Ag-ZnO5% | PVDF/Ag-ZnO10% | PVDF/Ag-ZnO20% | ||
|---|---|---|---|---|---|
| Pore surface in cross-section µm2/50 µm2 | 147 | 162 | 155 | 173 | |
| Average | Width µm | 9 | 9.3 | 9.6 | 10 |
| Lenghth µm | 34 | 42.2 | 48.4 | 54.6 | |
| Top surface | Pore count | 300 | 386 | 420 | 483 |
| Increase (%) | 29 | 40 | 61 | ||
| Bottom surface | Pore count | 260 | 280 | 323 | 363 |
| Increase (%) | 8 | 24 | 40 | ||
| Pore surface in bottom µm2/50 µm2 | 0.008 | 0.0165 | 0.0313 | 0.061 | |
| Porosity (%) | 80.8 ± 0.21 | 82 ± 2 | 86 ± 1.8 | 91 ± 0.24 | |
| Porosity increase (%) | 1.48 | 6.4 | 12.6 | ||
| Contact angle | 77.12 ± 0.54° | 77.4 ± 0.06 | 75.29 ± 0.85 | 68.61 ± 2.13 | |
| Permeability (L·h−1·m−2·bar−1) | 75.4 | 83.6 | 102.4 | 192.2 | |
| Enhanced permeability (%) | 11 | 36 | 155 | ||
| Membrane | PVDF | PVDF/Ag-ZnO 5% | PVDF/Ag-ZnO 10% | PVDF/Ag-ZnO 20% |
|---|---|---|---|---|
| Dye removal (%) | 24.2 | 31.5 | 39.8 | 56.0 |
| Efficacity enhancement (%) | 30 | 64 | 131 |
Disclaimer/Publisher’s Note: The statements, opinions and data contained in all publications are solely those of the individual author(s) and contributor(s) and not of MDPI and/or the editor(s). MDPI and/or the editor(s) disclaim responsibility for any injury to people or property resulting from any ideas, methods, instructions or products referred to in the content. |
© 2025 by the authors. Licensee MDPI, Basel, Switzerland. This article is an open access article distributed under the terms and conditions of the Creative Commons Attribution (CC BY) license (https://creativecommons.org/licenses/by/4.0/).
Share and Cite
Chamam, B.; Ben Dassi, R.; Abderraouf, J.; Mericq, J.P.; Faur, C.; Trabelsi, I.; El Mir, L.; Heran, M. Incorporation of Ag-ZnO Nanoparticles into PVDF Membrane Formulation to Enhance Dye Retention, Permeability, and Antibacterial Properties. Polymers 2025, 17, 1269. https://doi.org/10.3390/polym17091269
Chamam B, Ben Dassi R, Abderraouf J, Mericq JP, Faur C, Trabelsi I, El Mir L, Heran M. Incorporation of Ag-ZnO Nanoparticles into PVDF Membrane Formulation to Enhance Dye Retention, Permeability, and Antibacterial Properties. Polymers. 2025; 17(9):1269. https://doi.org/10.3390/polym17091269
Chicago/Turabian StyleChamam, Baha, Roua Ben Dassi, Jraba Abderraouf, Jean Pierre Mericq, Catherine Faur, Ismail Trabelsi, Lassaad El Mir, and Marc Heran. 2025. "Incorporation of Ag-ZnO Nanoparticles into PVDF Membrane Formulation to Enhance Dye Retention, Permeability, and Antibacterial Properties" Polymers 17, no. 9: 1269. https://doi.org/10.3390/polym17091269
APA StyleChamam, B., Ben Dassi, R., Abderraouf, J., Mericq, J. P., Faur, C., Trabelsi, I., El Mir, L., & Heran, M. (2025). Incorporation of Ag-ZnO Nanoparticles into PVDF Membrane Formulation to Enhance Dye Retention, Permeability, and Antibacterial Properties. Polymers, 17(9), 1269. https://doi.org/10.3390/polym17091269

